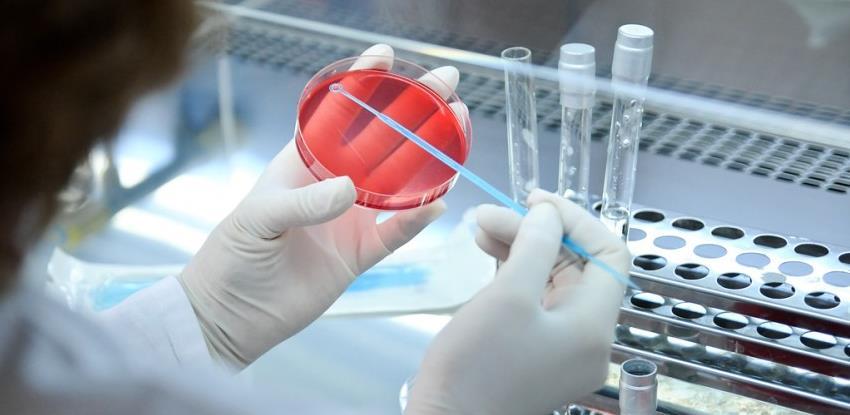

18.04.2023 |
Vijesti / BOSNA I HERCEGOVINA
Izvor: Nezavisne novine
Domaća piletina, iako je njen kvalitet na visokom nivou, teško se bori sa uvoznom, najviše sa onom iz Turske, a bh. peradari posebno upozoravaju na način deklarisanja te robe.
Domaća piletina, iako je njen kvalitet na visokom nivou, teško se bori sa uvoznom, najviše sa onom iz Turske, a bh. peradari posebno upozoravaju na način deklarisanja te robe.
"Imamo vrhunski proizvod kojem je glavna primjesa u hrani kukuruz, što se donekle razlikuje od Evrope jer je tamo počesto pšenica. Kvalitet mesa koji imamo znatno je bolji nego u mnogim dijelovima Evrope. S druge strane, imamo i standarde, kao što je halal, koji je vrlo popularan u Evropi. Jako se bunimo protiv odleđivanja, što je čak i zakonski kažnjivo, jednom zaleđena roba se smije samo jednom odlediti i nikada više. Tu imamo ozbiljnih problema. Inspekcije se bore protiv toga, ali ne u onoj mjeri u kojoj bismo mi željeli. Šta se to najviše uvozi iz Turske? U papirima je to mašinsko okošteno meso, a u stvarnosti znaju biti često neke druge stvari, to je problem. Deklaracija počesto ne prati pošiljku", kaže Edin Jabandžić, predsjednik Koordinacionog odbora peradara/živinara BiH.
BiH je sa Turskom potpisala međudržavne sporazume i otvorila joj svoje granice, navode iz Kancelarije za veterinarstvo BiH, između ostalog i za uvoz ove vrste proizvoda.
"Kako smo zaštitili naše proizvođače? Pa, na takav način što smo dozvolili da se iz Turske smiju uvesti samo smrznuti pileći filei koji su namijenjeni za preradu, a ne za konzum, odnosno za potrošnju u restoranima i u nekim drugim mjestima. Problem nastaje onog momenta kada se takva odluka zloupotrebljava. Mi smo to već uočili i određeni inspekcijski organi entiteta su utvrdili da se ti proizvodi troše, odnosno koriste na način kako to nije dozvoljeno. Kako možemo pomoći? Pa, pomogli smo na takav način što smo jako rigorozni pri izdavanju dozvola za uvoz mesa i mesnih prerađevina iz Turske", izjavio je Saša Bošković, direktor Kancelarije za veterinarstvo BiH.
O problemima koji ih muče peradari namjeravaju da raspravljaju na međunarodnom kongresu koji će biti održan u Banjaluci od 10. do 12. maja.
U ovoj oblasti je zaposleno više od 20.000 radnika, a za razliku od pilećeg mesa, domaća konzumna jaja lakše pronalaze put do bh. trpeza, ali i evropskih, jer firma "Agrex" iz Donjeg Žabara jedina iz BiH ima pristup evropskom tržištu.
"Doduše, iz BiH mogu ići jaja samo za industrijsku preradu i do ovog momenta smo bili prisutni na hrvatskom tržištu, italijanskom, slovačkom, češkom i otvaraju se čak sada potrebe i kada su Austrija i Mađarska u pitanju. S obzirom na probleme koji su se desili na evropskom tržištu, osjeća se manjak i stvaraju se mogućnosti za pojačani izvoz, ali mi samo redukovane ili ograničene količine izvozimo na spoljno tržište, čuvajući domaće tržište kao najvažnije, najbitnije i dugoročno tržište koje nas interesuje. Mi u najboljem slučaju nikada nismo izvozili više od 20 odsto naše ukupne proizvodnje", kazao je Predrag Miličić, direktor "Agrexa".
*Pri preuzimanju teksta s portala Akta.ba potrebno je navesti izvor i linkovati tekst.
Dojavi vijest na viber +387 60 331 55 03 ili na mail urednik@akta.ba.